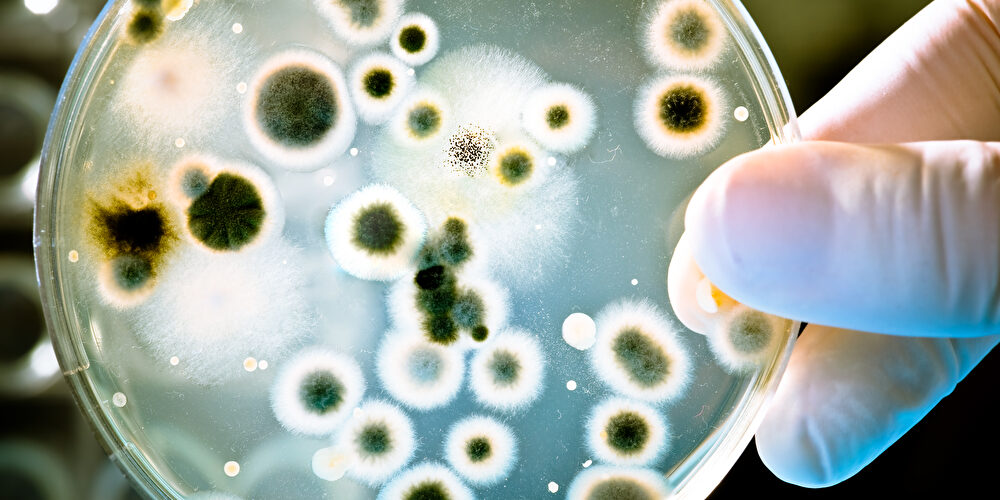

Vom Bauernhof ins All: Japan will Kuhmist als Raketentreibstoff nutzen
Ein ungewöhnlicher Ansatz zur Erforschung des Weltraums wurde von einem japanischen Start-up entwickelt. Statt konventioneller Treibstoffe setzt das Unternehmen auf einen Raketenantrieb, der ausschließlich mit Biogas aus landwirtschaftlichen Quellen betrieben wird. Das Erstaunliche daran ist, dass der Treibstoff aus Kuhmist gewonnen wird.

Japanisches Start-up testet Raketenantrieb mit umweltfreundlichem Biogas aus Kuhdung.
Foto: PantherMedia / CreativeNature
Der Umweltschutz gewinnt auch in der Raumfahrt zunehmend an Bedeutung. Ein japanisches Unternehmen arbeitet an einer unkonventionellen Lösung mit tierischem Ursprung, anstelle der herkömmlichen flüssigen und festen Treibstoffe. Wie bereits erwähnt, hat ein japanisches Start-up erfolgreich einen Raketenantrieb getestet, der ausschließlich mit Biogas aus landwirtschaftlichen Quellen betrieben wird. Der aus Kuhdung gewonnene Treibstoff ist nicht nur kostengünstig, sondern wird auch als umweltfreundlich betrachtet. Diese Informationen stammen von t3n unter Berufung auf Business Insider.
10-sekündige Explosion einer blau-orangen Flamme
Der erforderliche Treibstoff wurde vollständig aus dem Mist von Kühen zweier lokaler Milchviehbetriebe gewonnen, wie CEO Takahiro Inagawa berichtet. In Kooperation mit dem Industriegashersteller Air Water hat Interstellar eine Partnerschaft mit örtlichen Landwirten geschlossen, die die Ausscheidungen ihrer Kühe in Biogas umwandeln. Anschließend sammelte Air Water dieses Biogas und verwandelte es in Raketentreibstoff. Dieses Experiment, durchgeführt in der ländlichen Stadt Taiki, umfasste eine 10-sekündige Explosion einer blau-orangen Flamme.
Air-Water-CEO Takahiro Inagawa hebt besonders die geringen Herstellungskosten des speziellen Raketentreibstoffs hervor. Außerdem sei das Produkt nicht nur kostengünstig, sondern auch nachhaltig und zeichne sich zudem durch hohe Reinheit aus.
Inagawa plant, dass sein Unternehmen vorerst vorrangig die Raumfahrtambitionen Japans unterstützen wird, aber die Absicht besteht, den Treibstoff aus Kuhmist langfristig auch international bekannt zu machen.
Kohlenstoffneutrale Energie aus heimischer Produktion
Eiji Mizushita, ein teilnehmender Landwirt mit 900 Kühen, setzte ein automatisiertes System ein, um Mist in Biogas, Dünger und Einstreu zu verwandeln. Obwohl der Verkauf von Biogas für Mizushita nur geringe Einnahmen brachte, empfand er das Projekt als lohnend und betonte die Wichtigkeit einer korrekten Entsorgung von Tiermist. Er setzte sich für staatliche und gesellschaftliche Unterstützung bei der Produktion erneuerbarer Energien ein.
Tomohiro Nishikawa, ein Ingenieur von Air Water, betonte zudem, dass Japan nun kohlenstoffneutrale Energie aus heimischer Produktion gewährleisten muss. Er unterstreicht die Bedeutung, bereits über eine Energiequelle zu verfügen, falls sich in den internationalen Beziehungen etwas ändern sollte. Nishikawa hebt hervor, dass die Rohstoffe der Kühe aus der Region ein enormes Potenzial bieten. Denn: Trotz Rückschlägen in Japans „Moon Sniper“-Mission stellt der erfolgreiche Test des mit Kuhdung betriebenen Raketenmotors eine vielversprechende Entwicklung für das Raumfahrtprogramm des Landes dar.
Nutzung landwirtschaftlicher Abfallprodukte zur nachhaltigen Energiegewinnung
In einem Biogasreaktor kommen Mikroorganismen zum Einsatz, um den organischen Gehalt im Kuhmist abzubauen und dabei Methangas freizusetzen. Dieses Methangas dient als Brennstoff für die Energieerzeugung. Der Prozess bietet nicht nur eine alternative Energiequelle, sondern reduziert auch die Menge an Treibhausgasen, die durch den natürlichen Zersetzungsprozess von Mist in der Umwelt freigesetzt würden. Der verbleibende Gärrest wird nach der Biogaserzeugung als nährstoffreicher Dünger verwendet, um den Boden fruchtbarer zu machen und somit einen geschlossenen Kreislauf zu fördern. Biogas aus Kuhmist ist ein vielversprechendes Beispiel für die sinnvolle Nutzung landwirtschaftlicher Abfallprodukte zur nachhaltigen Energiegewinnung.
Biogas aus Kuhmist wird in verschiedenen Bereichen als erneuerbare Energiequelle genutzt. Landwirtschaftliche Betriebe mit beträchtlichem Tiermistvolumen können Biogasanlagen einsetzen, um sowohl Energie als auch Wärme für ihre Betriebe zu erzeugen. Zudem findet Biogas Anwendung in städtischen Umgebungen, wo es in spezialisierten Anlagen oder in Kombination mit anderen organischen Abfallquellen zur Energiegewinnung genutzt wird. Weltweit setzen auch größere Energieunternehmen auf Biogas als Teil ihres erneuerbaren Energiemixes. Die Vielseitigkeit von Biogas ermöglicht seine Anwendung in der Stromerzeugung, Wärmebereitstellung und sogar als Kraftstoff für Fahrzeuge.
Ein Beitrag von: